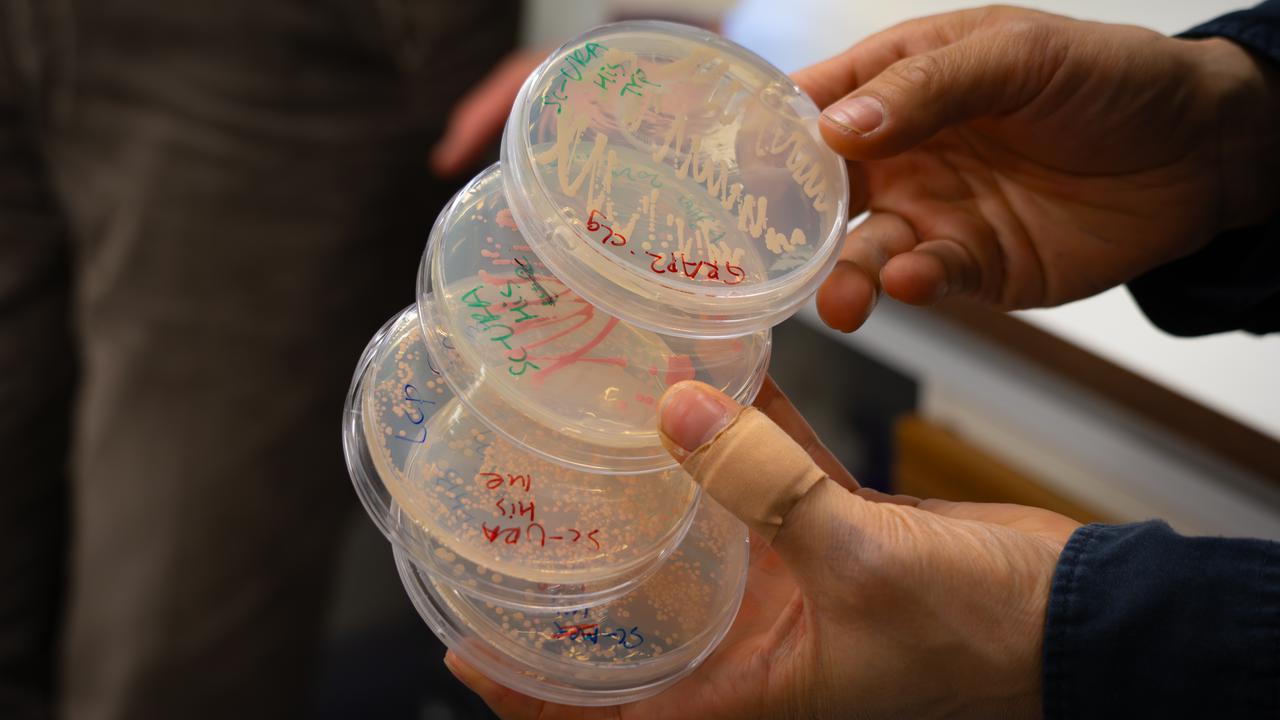
Närbild på fyra petriskålar med jästceller, noggrant uppmärkta.

Olika former av ätstörningar
Socialstyrelsen uppskattar att ungefär 200 000 personer i Sverige mellan 15–60 år lider av någon form av ätstörning, men man tror också att det finns ett mörkertal. De vanligaste formerna är hetsätningssyndrom, som innebär episoder med hetsätningar; bulimi, som innebär episoder med hetsätning följt av kompensatoriska beteenden som kräkning; samt ospecificerad ätstörning, som till exempel kan vara blandformer av de andra tillstånden.